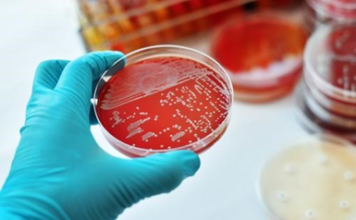
¿Qué es la difteria?

Olympus Digital, Tiene el Compromiso de Servir como Canal de Difusión de Información Veraz, Independiente y Plural en sus Contenidos.
Misión
Llevar a los Lectores Información Oportuna y Veraz, Asumiendo como Bandera Profesional, los Valores y Principios Éticos, para Influir Positivamente en la Construcción de una Cultura de Paz y Respeto Mutuo.
Visión
Ser el Diario Digital Líder en Medios de Información y Opinión a Nivel Nacional e Internacional, con Independencia Periodística, Pluralidad de Criterios, Apegados a la Ética y a la Moral.